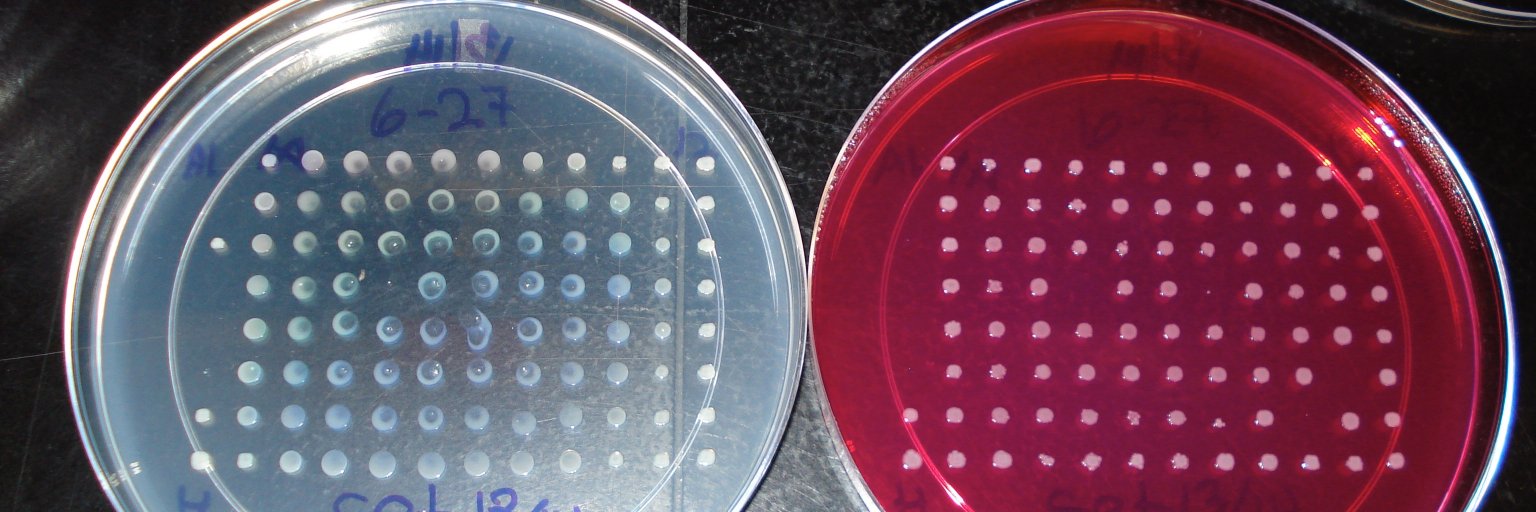
Dr. Dr. Helene Andrews-Polymenis, banner

Dr. Dr. Helene Andrews-Polymenis,
18.3K posts

@HPolymenis
Bacteriologist. Veterinarian. Teacher. Mom. Wife. Daughter. Sister. Mentor. Fighter for social justice.PDAC survivor 6 yrs. @hpolymenis.bsky.social
















RFK Jr. adviser: We’re trying to get kids with autism into vaccine injury program ow.ly/exQx106mIVo







RFK Jr.: "Gardasil is probably the single worst mass vaccine that we've ever seen. This vaccine targets millions of preteens and teens for whom the risk of dying from cervical cancer is zero. Nobody in their right mind would ever take this vaccine if they actually read the clinical literature." "Death rates in the Gardasil trials were 37 times the death rates for cervical cancer. Children who take that vaccine, the Gardasil vaccine, are 37 times more likely to die from the vaccine than they are to die from cervical cancer. The problem with Gardasil, like most vaccines, is it was never tested against a true placebo, an inert placebo." "And the CDC and HHS say, if you don't test it against a true placebo, it's not science. You have no way of gauging whether the injuries you're seeing from the product are being caused by that product, or whether they're just bad, sad coincidences. The entity that is actually performing the study is, and paying for the study, is Merck." "Merck got to decide which injuries were being caused by Gardasil and which were just bad coincidences. And because it had that power, it just wrote them all off as bad coincidences." "You can do that when there's no placebo, because the injuries they were seeing in the control group, where the girls were getting aluminum neurotoxins, were identical to the injuries they were getting in the Gardasil group." "So they said, well, we don't have to report any of these as vaccine injuries. They were able to license something that is insanely dangerous."


